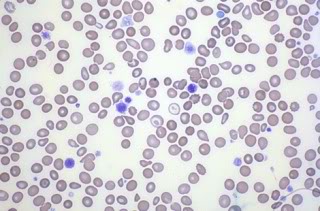

Not EMC, I can happily say it is not EMCBut then some support guys are seen as "uncaring so-and-so's" from all companies so the few can taint it for the many.
Now it may get as hot as "F" there but I still want to move there when I get the chance, not necessarily your building though, but the Pittsburgh area in general.
Good... dealing with an issue with techs not showing up to one of our remote sites right now, ready to kill someone.
Not really hot here, most of the time. We just went through a heat wave where it was above 90 for almost 3 weeks in a row, that is unusual for a summer as we usually only see 6-7 90+ days. The sys admin area for our area is in a corner of the building on one of the top floors, its probably 20* warmer here on some days then it is in the middle of the floor.